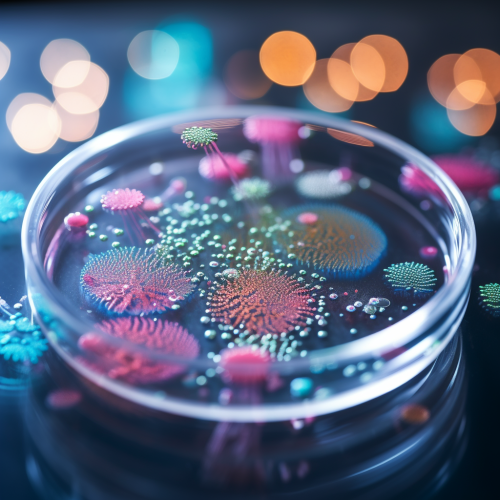
Bacteria on Petri Dish
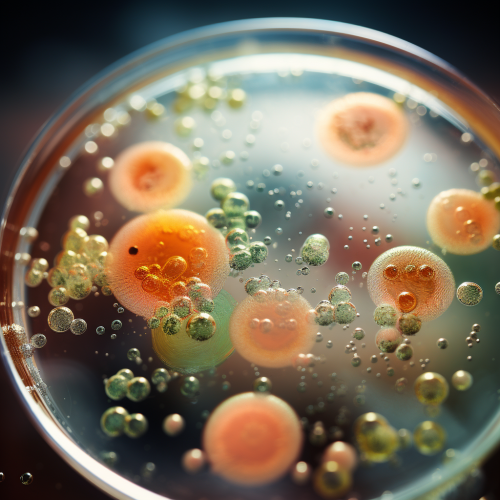
Bacteria on Petri Dish
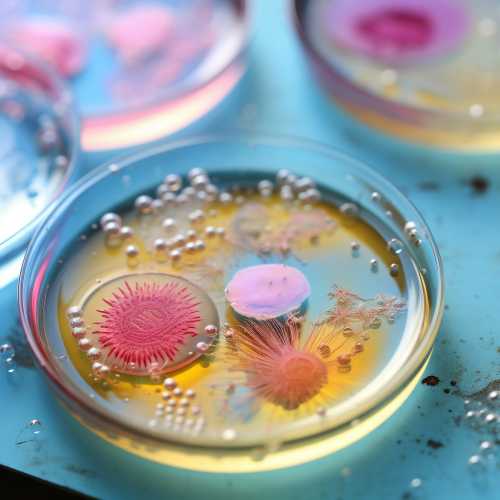
Bacteria on Petri Dish

Bacteria on Petri Dish
Prompt
License
Free to use with a link to 2moonsai.com
Similar Images
a complex image where the front center is a large Legionella bacteria in a circle, and the background is a computer dashboard with scientific graphs and coding, intricate details, high resolution, --ar 4:3 --v 6.0
bacteria, virus, colourful, graphic, clear white background --s 750
RECIPE NAME: Peperoni arrosto | Amateur photo from reddit, taken with an iPhone 15 Pro. | SHOT TYPE: taken in a kitchen in front off the window on table
an animation drawn in the style of studio. Ghibli of a luxurious petri display featuring rose of pastel colored macarons and soft shades of mint green, pink, lavender cream and chocolate, brown, organize neatly inside the glass case golden framed signs and a red apple shaped decoration, adorn the counter ornate brass lamps with white lamp shades illuminate the scene with a warm glow the background is filled with pastel coloredgift boxes, evoking an elegant high-end atmosphere
чашка петри restaurant, interior, bright, space style, spaceship, large, space aesthetics, with details of bacteria that are being taken to another planet, plants, bacteria, flasks with plants, magnifying parts of bacteria show flasks in the interior with plants, magnifying mirrors with plant molecules, plants, plants in space, plants on another planet, realistic, detailed; wide-angle, highly detailed, octane render, natural lighting, massive scale real photo, ambient light, realictic render, high quality photo photorealistic render, high detail cgrender cginterior
elevation photo of a building appearing to be grown from translucent capsules appearing like petri dish with bright mould inside. Deconstructionist architecture. Located on a block in New York. It is a Multi storey building. The building is Avant garde experimental designed architecture. Complex structural elements. Symmetry.
a complex image with a large Legionella bacteria in the front, background is a slightly faded computer dashboard with green vertical letters like the matrix, --ar 3:2 --v 6.0
An illustration, of a man holding a child in his arms with a flame torch, he is keeping bacteria at bay with it, done in the style of a survival guide,
An iconographic illustration of a bacteria, done in the style of a survival guide, yellow and black very simple illustration
very simple iconographic illustration of a bacteria, yellow and black
a diorama of a landscape of bacterial and fungal colonies --ar 113:160 --style raw --stylize 300 --v 6.0
An iconographic illustration of a bacteria, done in the style of a survival guide, yellow and black illustration

View Limit Reached
Upgrade for premium prompts, full browsing, unlimited bookmarks, and more.
Get Premium
Limit Reached
Upgrade for premium prompts, full browsing, unlimited bookmarks, and more. Create up to 2000 AI images and download up to 3000 monthly
Get Premium
Become a member
Sign up to download HD images, copy & bookmark prompts.
It's absolutely FREE
 Login or Signup with Google
Login or Signup with Google

Become a member
Sign up to download HD images, copy & bookmark prompts.
It's absolutely FREE
 Login or Signup with Google
Login or Signup with Google

Limit Reached
Upgrade for premium prompts, full browsing, unlimited bookmarks, and more.
Get Premium

Download Image (SD)
Download Image (SD)
 Download Image (HD)
Download Image (HD)




















